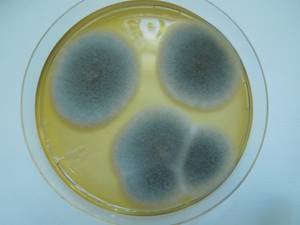
MSU_FS-01577 01, Район Тан Фу (Tân Phú districts), Đồng Nai province (Vietnam)

Total items: 4
Total pages: 1
Organisms

- Specimen ID
- 0000000905404
- Species
- Monodictys castaneae
- Strain
- MSU_FS-02309
- Place of isolation
- Район Быон Дон (Buôn Đôn district), Đắk Lắk province (Vietnam)
- Placename
- Кронг На (Krông Na)

- Specimen ID
- 0000000905242
- Species
- Monodictys castaneae
- Strain
- MSU_FS-02219
- Place of isolation
- Район Быон Дон (Buôn Đôn district), Đắk Lắk province (Vietnam)
- Placename
- Кронг На (Krông Na)
- Specimen ID
- 0000000904454
- Species
- Monodictys castaneae
- Strain
- MSU_FS-01577
- Place of isolation
- Район Тан Фу (Tân Phú districts), Đồng Nai province (Vietnam)
- Placename
- Нам Кат Тьен (Nam Cát Tiên)

- Specimen ID
- 0000000903668
- Species
- Monodictys castaneae
- Strain
- MSU_FS-00887
- Place of isolation
- Район Лак Дыонг (Lạc Dương district), Lâm Đồng province (Vietnam)
- Placename
- Да Чаис (Đạ Chais)